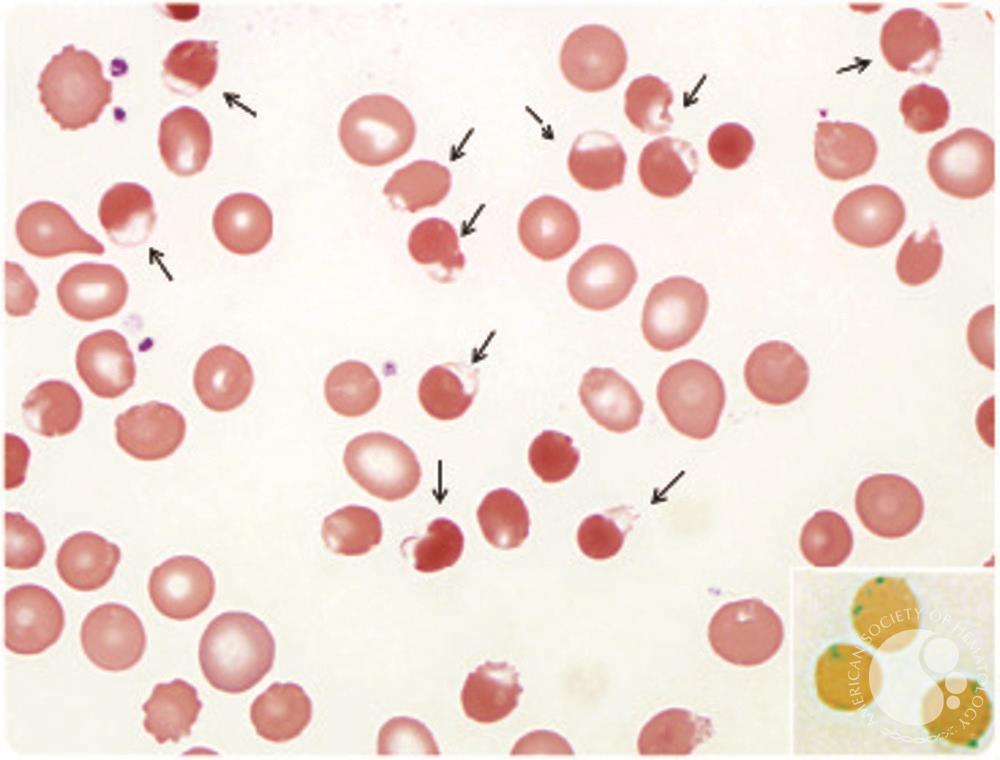
Rasburicase-induced Heinz body hemolytic anemia in a patient with chronic lymphocytic leukemia Rasburicase-induced Heinz body hemolytic anemia in a patient with chronic lymphocytic leukemia
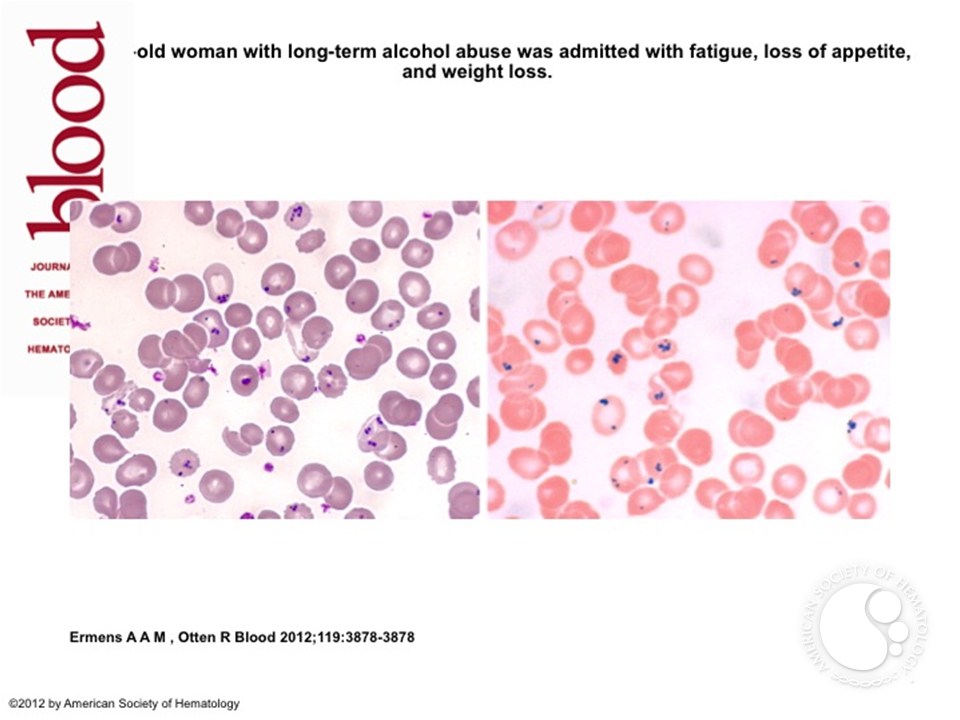
Pappenheimer bodies in a splenectomized patient with alcohol abuse Pappenheimer bodies in a splenectomized patient with alcohol abuse

What's the difference between Howell-Jolly bodies and Heinz bodies? | Pathology StudentThe university loves Heinz's bodies and Howell-Jolly's bodies. The inclusion bodies of the RBC have appeared in several SAQs, and are often associated with a question about post-plenectomy vaccination. More often, the question is 10-20% of a multi-part question, and represents easy marks for the person who can remember a handful of differentials. So far, the university has not asked anything about siderocytes or basophile stippling. The Representative of United Nations Special Headquarters in Africa understands the following: Howell-Jolly bodies are leftover pieces of DNA in the erythrocytes. Normally, the spleen would consider these as defective, and would be eliminated. They are typically seen in patients who have had a splenectomy. Other associations include the following conditions: Heinz bodies, also known as Heinz- Ehrlich bodies are essentially small amounts of denatured haemoglobin within the red cells. They usually indicate some type of oxidative stress. This type of abnormality is usually observed in the disorders of the metabolism of red cells and haemoglobinopathies. Additionally, a normal individual probably has a few RBCs with Heinz bodies, but they are quickly cleaned by splenic macrophages (and so after splenectomy they start to accumulate). Increased oxidative stress due to to toxins Unstable Haemoglobins Deranged RBC metabolismDecreased clearance of defective RBCsMiscellaneous RBC inclusion bodies: Ampoule cells: surface stains of the RBCs, suggestives of oxidative damage; view with G6PD deficiency and in several states of oxidative stress, for example, dapsone or primane toxicity. Within the same film one could expect a few Heinz bodies. Pappenheimer's Corps: granules containing weiderin seen in steel anemiaBasic constipation: ribosomes altered in cytoplasm; seen with lead poisoningPrevious title: Morphologic abnormalities of red blood cells Chapter following: Leukemoid Reaction ReferencesKyle, R. A. Rajkumar. Vkumar. Leukemia 23.1 (2009): 3-9.Fadem, Robert S., and JOHN E. McBIRNIE. Blood 5.2 (1950): 191-200. Aherne, W. A. Journal of clinic pathology 11.4 (1958): 326-329.Constantino, Benie T., and Bessie Cogionis. Lab Medicine 31.4 (2000): 223-229.SCHMIDT, JOHN J., HAROLD J. ROBINSON, and CHARLES S. PENNYPACKER. Annals of internal medicine 59.4 (1963): 542-546. Bäumler, H., et al. Biorheology 36.5 (1999): 439-442.Wagner, Christian, Patrick Steffen and Saša Svetina. Compte Rendus Physique 14.6 (2013): 459-469. REPLOGLE, ROBERT L., HERBERT J. MEISELMAN, and EDWARD W. MERRILL. Circulation 36.1 (1967): 148-160.Ponder, Eric. Experimental physiology 15.3 (1925): 235-252.Aslinia, Florence, Joseph J. Mazza, and Steven H. Yale. Clinical medicine " research 4.3 (2006): 236-241.Walker, H. Kenneth, et al. (1990). Clinical Methods: History, Physics and Laboratory Examinations. 3rd edition. Bessis, Marcel. Corpusculos. Springer Berlin Heidelberg, 1974. 59-64. Jones, Kathy W. I don't know what textbook is this form, but it's a chapter that's available free online... for now. Bull, BRIAN S., J. Breton-Gorius, and E. Beutler. "New York, McGraw Hill (2001): 271-288. - This is an online refueling of a Williams Haematology chapter, but no figures. Corazza, G. R., et al. Clinical " Laboratory Haematology 12.3 (1990): 269-275. Barbara J. New England Journal of Medicine 353.5 (2005): 498-507.Sakka, Vissaria, et al. European journal of internal medicine 17.6 (2006): 394-398.ul Haque, Anwar and Noor ul Aan. International Journal of Pathology 8.1 (2010): 39-40. HARLEY, JOHN D., and ALVIN M. MAUER. Blood 17.4 (1961): 418-433.JANDL, JAMES H. Annals of internal medicine 58.4 (1963): 702-709.
Heinz bodies vs. Happy bodies Heinz bodies Happy bodies REFERENCES Winterbourn CC, Carrell RW. Hemoglobin Denaturation Studies and Heinz Corporal Formation in the Inestible Hemoglobins. Journal of Clinical Investigation. 1974;54(3):678-689. Webster, Stewart. Fenomenón del Corps Heinz en Eritrocitos. Blood 1949 4:479-497 Internal Medicine Recent publications Although synonyms are often used; Trapped Lung and Lung Entrapment technically describe separate entities throughout the... It is not clear why patients with pulmonary hypertension (PH) develop pericardial dermorrhages. However, both drugs are not interchangeable or equivalent doses. Mycophenolate mofetil (Cellcept) is a semi... Serum creatinine can be a misleading substitute during acute kidney injury. You can wash... Macrophogen Activation Syndrome (MAS) is a complication that threatens the life of rheumatic diseases (e.g. SLE, Junior Idiopathic... After the creation of a percutaneous tracheotomy site for prolonged ventilation, one of the immediate complications... This website uses cookies.

Heinz bodies vs. Howell jolly bodies | Medicine Specifics
Inclusion Bodies of Red Blood Cells – The Art Of Medicine
Inclusion Bodies of Red Blood Cells – The Art Of Medicine
Red Blood Cell Disorder -- Heinz bodies, Howell-jolly bodies, basophilic stippling & Reticulocytes - YouTube
Howell–Jolly body - Wikipedia
Howell-Jolly bodies and Heinz bodies | Hematology, Medical laboratory, Medical technology labs
Howell-Jolly Bodies - YouTube
Rasburicase-induced Heinz body hemolytic anemia in a patient with chronic lymphocytic leukemia
Inclusion Bodies of Red Blood Cells – The Art Of Medicine
What is the Howell-Jolly body? | Stanford Medicine 25 | Stanford Medicine
Hematology Images 5 Flashcards | Quizlet
Figure 16 from The feline blood film: 1. Techniques and erythrocyte morphology | Semantic Scholar
A: basophilic stippling. B: Howell-Jolly bodies. C: Cabot's rings. D: Heinz bodies | Medical laboratory, Medical technology, Medical laboratory scientist
basophilic stippling – howel jolley bodies – Cabot Ring – Heinz bodies | Medical Laboratories
Heinz Bodies – Cells and Smears
Inclusion bodies - red blood cell inclusions bodies|details|microscopic photos - YouTube
Heinz body - Wikipedia
Pathologic Red Blood Cell (RBC) Morphologies and Associated ... | GrepMed
Pappenheimer bodies in a splenectomized patient with alcohol abuse
Inclusion Bodies of Red Blood Cells – The Art Of Medicine
Hematology Unit Lab 1 Review Material
Howell Jolly Bodies | Medical Laboratories
HematologyOutlines - Atlas
Les corps de Howell-JolyE
Howell jolly bodies vs Heinz body - Health Care Tips and Natural Remedies
Pappenheimer bodies - Wikipedia
Inclusion Bodies of Red Blood Cells – The Art Of Medicine
Heinz Bodies and Bite Cells - YouTube
HematologyOutlines - Atlas
Image result for howell jolly bodies image | Body, Body image, Stain
Hematology basics pt 1 jpg
Inclusion Bodies of Red Blood Cells – The Art Of Medicine
HematologyOutlines - Atlas
Basophilic stippling and Howell-Jolly bodies![David Steensma, MD on Twitter:]()
David Steensma, MD on Twitter: "H-J bodies are commonly mistaken for Heinz bodies. But you don't see Heinz bodies with Wright stains; you need a supravital stain or "Heinz body prep". They're
Howell–Jolly body - Wikipedia
Heinz Bodies - YouTube
HematologyOutlines - Atlas
Inclusion Bodies of Red Blood Cells – The Art Of Medicine
Basophilic Stippling - an overview | ScienceDirect Topics
Posting Komentar untuk "heinz bodies vs howell"